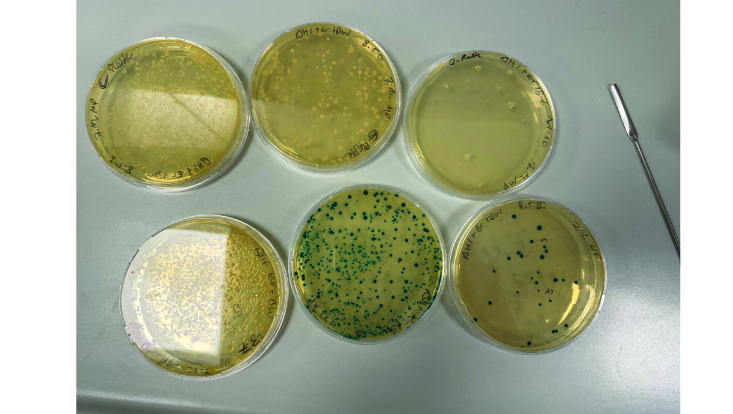
blau-weiss-srceening-melina-733x414 Blau-Weiß Screening

Arbeitsgruppe Prof. Dipl.-Ing. Dr. Weiß
Herzlich Willkommen
... in der Arbeitsgruppe Lebensmittelmikrobiologie. Wir erforschen die Interaktion von Mikroorganismen und Lebensmitteln, um die Lebensmittelsicherheit zu gewährleisten und den Verderb zu verhindern. Ein weiterer Fokus ist die gezielte Auswahl und Charakterisierung von Starterkulturen.
Unsere Schwerpunkte in der Forschung sind:
- Mechanismen der Inaktivierung von bakteriellen Verderbern und Pathogenen in Lebensmitteln durch konventionelle und nicht-thermische Verfahren, mit Schwerpunkt Fruchtsäfte
- Bedeutung von Nutzpflanzen als Sekundärwirte für Humanpathogene und pflanzliche Lebensmittel als Überträger von bakteriellen Infektionen und Intoxikationen
- Einsatz von „omics“ Technologien zur Charakterisierung von Fermentationsorganismen und gezielter Selektion von Starterkulturen
In der Lehre unterrichten wir derzeit in den Studiengängen:
- B.Sc. Lebensmittelchemie
- M.Sc. Lebensmittelchemie
- Bachelor-Teilstudiengang Ernährungs- und Haushaltswissenschaften innerhalb der Lehramtsstudiengänge
- Master- Teilstudiengang Ernährungs- und Haushaltswissenschaften für das Lehramt an beruflichen Schulen
- M.Sc. Kosmetikwissenschaft
- Master-Teilstudiengang Kosmetikwissenschaft für das Lehramt an beruflichen Schulen
Wir betreuen Bachelor- und Masterarbeiten in allen genannten Studiengängen.
Öffentliche Ringvorlesung: Lebensmittel – Was esse ich da überhaupt?
Im Wintersemester 2025, mittwochs von 17 Uhr bis 18 Uhr, Hörsaal B, Martin-Luther-King-Platz 6
Erfahren Sie hier mehr zur Veranstaltung und den einzelnen Terminen.